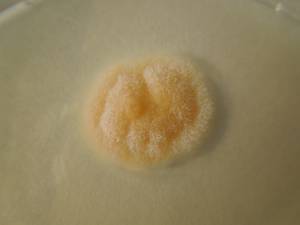
MSU_FS-02215 01, Район Тан Шон (Thanh Sơn district), Провинция Бенче  (Phú Thọ Province) (Вьетнам)

Всего записей: 2
Всего страниц: 1
По организмам

- ID образца
- 0000000905236
- Вид
- Gliocladiopsis irregularis
- Штамм
- MSU_FS-02216
- Место сбора
- Район Тан Шон (Thanh Sơn district), Провинция Бенче (Phú Thọ Province) (Вьетнам)
- Топоним
- Суан Шон (Xuân Sơn commune)
- ID образца
- 0000000905234
- Вид
- Gliocladiopsis irregularis
- Штамм
- MSU_FS-02215
- Место сбора
- Район Тан Шон (Thanh Sơn district), Провинция Бенче (Phú Thọ Province) (Вьетнам)
- Топоним
- Суан Шон (Xuân Sơn commune)